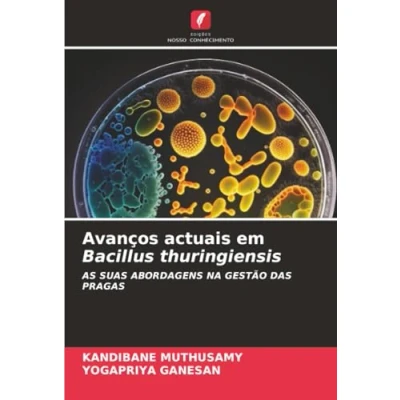

Avanços actuais em Bacillus thuringiensis: AS SUAS ABORDAGENS NA GESTÃO DAS PRAGAS
Prices from
COMPARE ALL WEBSHOPS
(2)
Amazon
Pages: 96, Paperback, Edições Nosso Conhecimento
Read more
38.00
Featured

|
£ 38.00 |
To Shop
|

|
£ 38.00 |
To Shop
|
 Description
Description
Amazon
Pages: 96, Paperback, Edições Nosso Conhecimento
Pages: 96, Paperback, Edições Nosso Conhecimento
Prices were last updated on:

Product specifications
Product specifications Related
Related 



